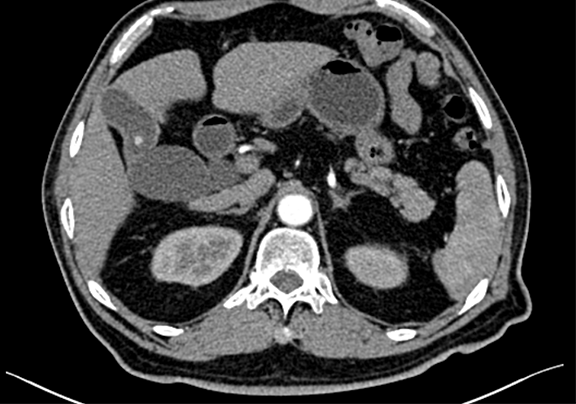

肝组织化脓性炎症-CH-001-LT-000368
一般情况:CH-001-CT-000368,70岁男性,身高158cm,体重70kg,
主诉:查体发现肝占位9天。
现病史:患者9天前无明显诱因查体发现肝内占位性病变,右侧肋缘下轻度触痛,无区域放射,尚可耐受,与体位、活动无关,偶发间断性头晕、头痛,自诉50余年胆囊结石病史,无予以特殊治疗及药物服用,无恶心、呕吐,无腹痛、腹胀,无右侧肩部放射痛,无胸闷、胸痛,无咳嗽、咳痰,无睡眠障碍,小便轻度尿刺痛感,饮食正常,2016-05-23于我院行健康查体显示:肝脏体积正常,肝内呈细密点状回声,欠均匀,探及一枚等低回声结节,大小约6.0cm ×5.0cm 呈椭圆形,内部回声较均匀,胆囊大小形态正常,毛糙,内见一乳头样高回声,大小约0.7cm ×0.6cm 不随体位移动,后方无声影,囊腔内可见强回声,呈泥沙样及胆泥样,范围约4.2cm× 1.9cm 后伴声影,随体位改变移动。脂肪肝(轻度)肝内结节 考虑血管瘤,建议CT随访,胆囊息肉,胆囊炎并胆囊结石,患者自发病以来未予以特殊治疗及用药。
查体:腹部平坦,对称,无腹壁静脉曲张,无胃肠型和蠕动波,腹部柔软,右侧肋缘下轻度压痛,无反跳痛,未触及异常包块。肝、脾肋下未触及、质软、无压痛,Murphy氏征阴性。腹部叩诊:肝上界在右锁骨中线第五肋间,肝、肾区无叩击痛,无移动性浊音。肠鸣音正常,4次/分。未听到血管杂音。
整理:崔楷悦,吴萤 3D:周显军,朱呈瞻